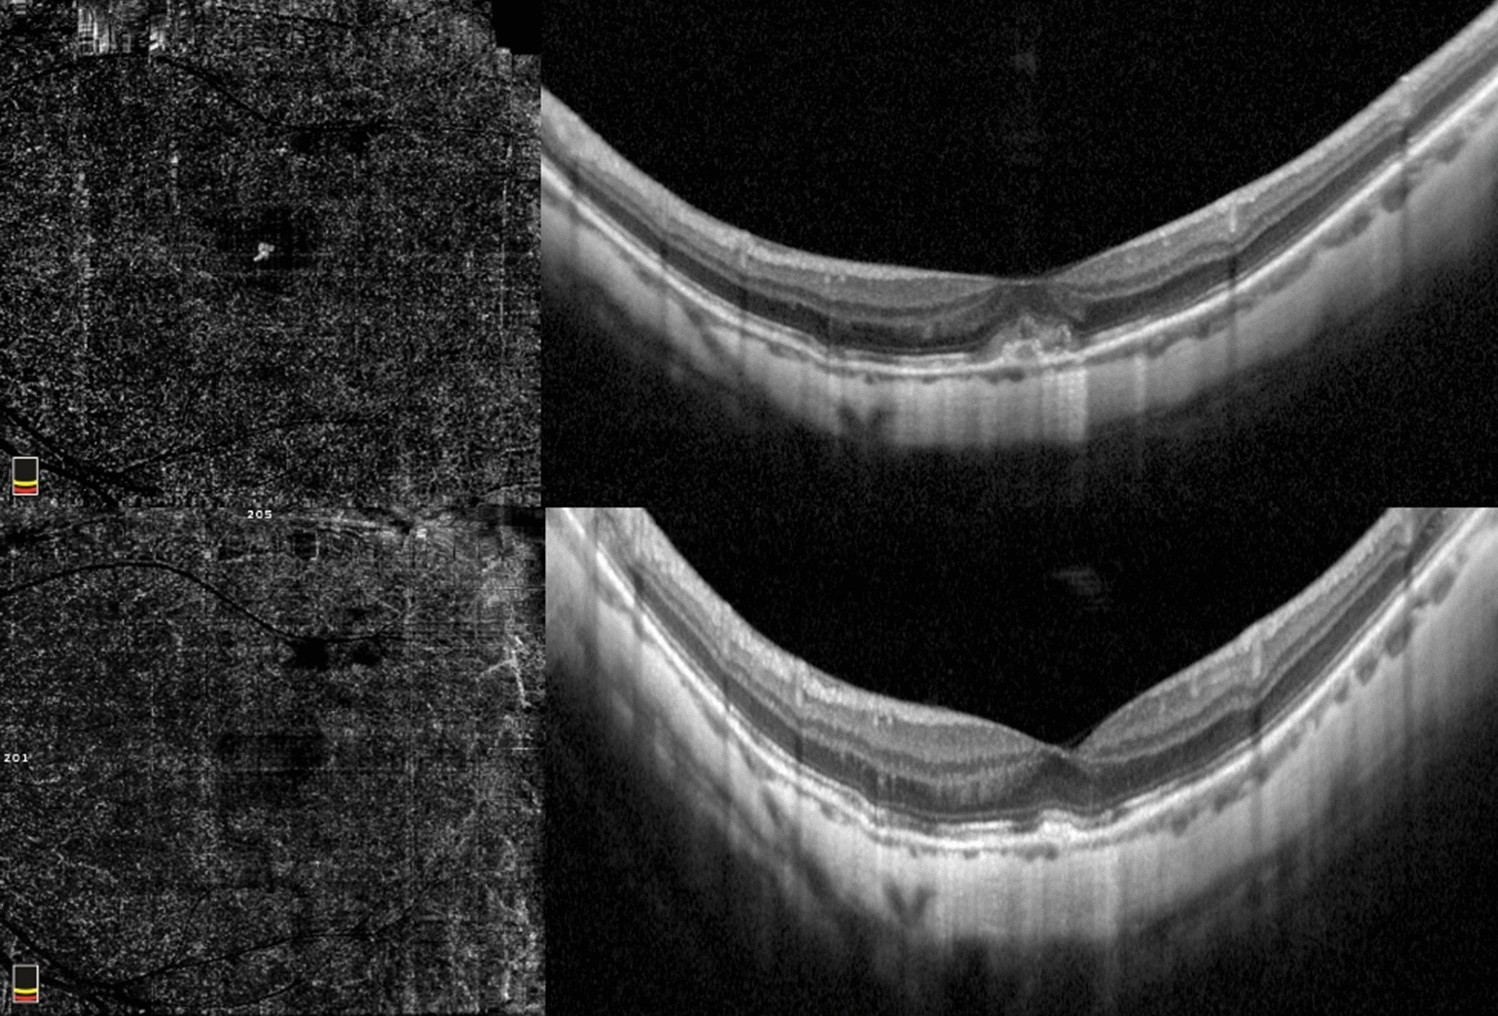
Figure 1

Figure 1
Immature myopic CNV. Baseline OCTA examination of a case of immature subfoveal myopic CNV (top left). The corresponding SD-OCT image shows the hyperreflective subretinal exudation with fuzzy borders, absence of intraretinal cysts and subretinal fluid (top right). OCTA at the final visit (12 months) after two intravitreal injections highlight the complete regression of the neovascular network (bottom left) and SD-OCT scan shows the disappearance of the subretinal material (bottom right).
